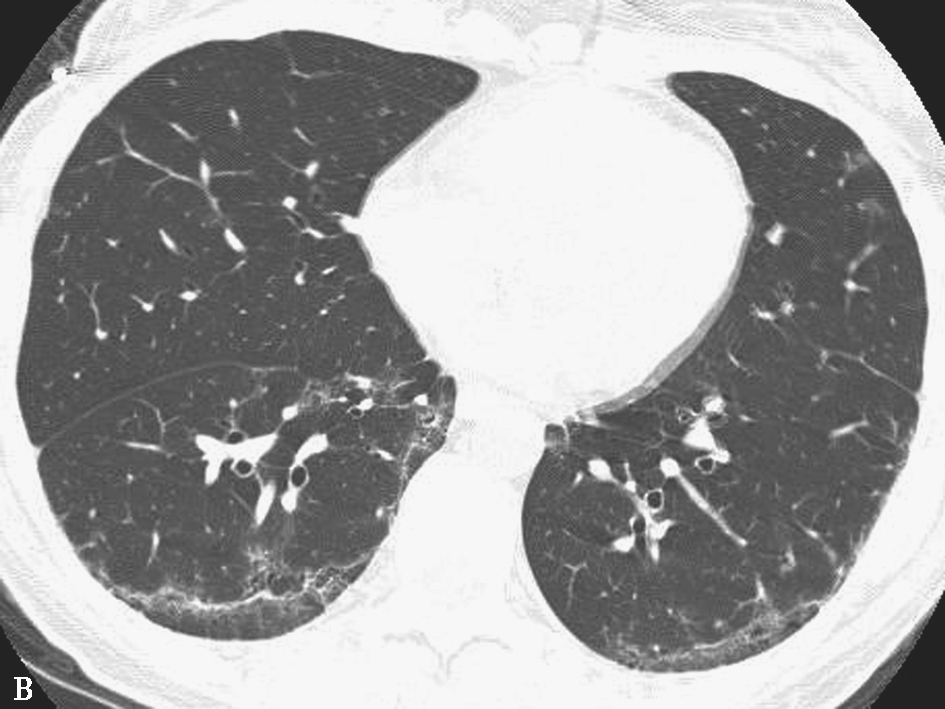

呼吸系统疾病在我国属于常见疾病,其他各系统疾病也经常累及肺部。影像学检查不仅能反映患者呼吸系统的形态学改变,也能反映其功能变化。无论是在临床诊疗过程还是科学研究中,影像学均发挥着极为重要的作用。
本节主要介绍各种影像学检查方法的特点、X线胸片及计算机断层扫描(computed tomography,CT)的主要征象以及影像分析思路。而对于胸部正常影像解剖和呼吸系统具体疾病的影像学表现不在此赘述。
胸部X线摄影一直是呼吸系统疾病影像诊断中最常用,也是最基本的检查方法。胸部X线摄影常规需投照正、侧位像,以比较准确地定位病变之所在。X线胸片结合详细的临床资料,能够帮助临床医师对大多数呼吸系统疾病做出诊断或缩小鉴别诊断的范围。然而,X线胸片也存在明显不足:①密度分辨率仍较低,故对纵隔及胸壁病变只有在轮廓或形态有明显变化时才能显示;②由于前后组织结构互相重叠,使肺门区、纵隔旁、心后和近横膈区等部位的病变难于显示;③对弥漫性病变诊断的敏感性及准确性较低。
常规CT具有良好的密度分辨率和横断图像无组织结构重叠的优点。高分辨率CT(high resolution computed tomography,HRCT)技术的应用,使CT能更清晰地显示肺组织结构的细节,已达到或接近大体标本的分辨能力,显著地提高对肺部病变的诊断和鉴别诊断价值。近年来,多层螺旋CT技术的广泛运用,特别是64排或以上CT设备,能实现通过一次屏气在几秒内用<1mm准直扫描整个胸腔,获得真正的全胸部容积数据,实现在任意平面观察图像,并且重建任意平面的最大密度、最小密度投影,以及三维成像。随着计算机硬件和软件迅速发展,CT成像各种后处理技术日臻完善,使得对呼吸系统结构和病变进行定量观察成为可能。另外,功能性检查和能谱成像的运用,使CT不仅能显示形态学变化,还可以进行功能性检查,甚至分子成像,为开展呼吸系统精准诊疗发挥作用。
肺部HRCT的基本条件是薄层扫描(0.5~1.25mm)和图像重建使用高空间频率算法。多层CT采集数据后,可直接重建出连续薄层图像,无须单独进行扫描。对于大多数呼吸系统疾病的胸部CT检查,采用平扫基本可以满足临床诊断。CT增强扫描主要用于纵隔病变和肺局灶性病变,特别是怀疑有大血管病变时,如检查是否有肺动脉栓塞等。
磁共振成像具有无创、无放射性损伤的特点,同时具有判断组织化学特性的潜力,能提供软组织和肺内含水程度,以及组织血流等的定量和定性信息,并具有直接多层面扫描方式等优点。然而,影响磁共振在呼吸系统疾病诊断上广泛运用的因素也比较明显,主要包括:①仍然难以解决因心脏搏动和呼吸所产生的运动伪影;②充气肺组织内,含水肺组织结构和循环血只占全肺容积的10%~20%,通常无法提供足够的诊断信息;③肺内存在无数气体与软组织介面,使磁场不均匀,信号丢失;④肺组织本身T2弛豫时间短,降低了所获得信号的质量。
总体上,目前磁共振成像在呼吸系统疾病影像检查中运用的广泛性及重要性仍远不及CT,仅作为二线检查方法,补充解决一些临床问题。随着磁共振技术的发展,结合其本身特性,希望在未来发挥更重要的作用。
核素检查在呼吸系统疾病诊断中运用不多,对于怀疑肺动脉栓塞的患者,进行核素通气/灌注扫描曾经是首选影像学检查方法,但随着多层CT的广泛运用,该技术已逐渐被CT肺动脉造影(computed tomography pulmonary angiography,CTPA)所替代,目前主要适用于检查可疑肺栓塞但对碘造影剂过敏患者、孕妇或肾功能不全患者。
正电子发射型计算机断层扫描显像(positron emission tomography/computed tomography,PET/CT)能评价胸部病变的代谢状态,目前常用于肿瘤性病变的诊断和鉴别诊断,尤其对肿瘤分期和疗效评价具有较高价值,但是由于费用较高,同时存在一些假阳性和假阴性,在一定程度上限制了该技术的广泛运用。
从病理学角度来看,肺实变是肺泡腔内气体被液体、蛋白、组织细胞或其他物质所替代。其影像学表现特征如下。
X线胸片:显示为肺内组织密度增高,边缘清楚或模糊,肺野内可伴或不伴充气支气管征,局部肺体积无明显缩小(图1-2-1)。判断肺体积缩小的征象主要包括叶间裂移位、纵隔和肺门向患侧移位,患侧膈肌上升。

图1-2-1 右上叶大叶性肺炎X线胸片表现
男性患者,86岁,发热5天。X线胸片显示右上叶大片实变影,上缘模糊,下缘平水平裂,边界清楚,水平裂未见明显移位,右肋膈角钝,右膈肌外侧升高(胸膜粘连所致)
CT:斑状或片状密度增高影,边缘模糊,当实变影蔓延至叶间胸膜时可形成锐利边缘,受累肺叶体积正常或可有轻微改变,在CT平扫时病灶掩盖其中的肺血管,常可见支气管充气征(图1-2-2)。增强CT扫描时可见病灶内血管影且分布正常。


图1-2-2 右上叶大叶性肺炎胸部CT平扫
与图1-2-1相同患者。胸部CT肺窗(A)显示右上叶大部分实变,内见充气支气管征,右上叶支气管未见阻塞;纵隔窗(B)显示右上叶实变呈软组织密度,未见明确坏死灶
肺实质出现实变影可有两种主要形式:①单发或多发局灶性实变影;②弥漫性实变影。
是感染性炎症最常见的表现,病因很多,主要包括细菌性肺炎、支原体肺炎、机化性肺炎、放射性肺炎、肺出血、肺腺癌、血管炎和肺梗死,单纯依据影像学表现不易直接进行诊断和鉴别诊断。如果病变边缘模糊,多考虑急性炎症、肺出血或血管炎;如果边界较清楚,多考虑相对慢性的病变,如机化性肺炎、肺腺癌、原发性肺淋巴瘤,在随诊观察中显示病灶变化较缓;如果肺叶实变影以叶间裂为边界,伴叶间裂膨隆,考虑为肺炎克雷伯菌所致肺炎可能较大(须注意,这一征象在X线胸片有一定提示价值,但不适合于CT);如果实变影内出现液化坏死病灶,应考虑坏死性炎症的可能,如金黄色葡萄球菌性肺炎、军团菌或厌氧菌感染;如果下肺胸膜下出现楔形影,尖端指向肺门区,应考虑肺梗死可能。临床表现和一些实验室检查对于临床诊断有时具有决定性作用,如咯血对诊断肺出血有明确价值。局灶性实变影的一个特殊形式是实变影呈球形,边缘通常较模糊(图1-2-3),最常见于球形肺炎,也可见于局灶性机化性肺炎或肺梗死。多灶性实变影多见于小叶性肺炎、真菌性感染和吸入性肺炎,偶尔也可见于肉芽肿性多血管炎(旧称韦格纳肉芽肿)和肺腺癌(图1-2-4)。


图1-2-3 右下叶球形肺炎X线胸片和胸部CT平扫
女性患者,60岁,咳嗽、发热3天。X线胸片(A)显示右下肺类圆形密度增高影,边界较模糊;胸部CT肺窗(B)显示右下叶前基底段类圆形实变影,内见充气支气管征,病变边缘模糊,部分可见磨玻璃影


图1-2-4 两侧黏液腺癌胸部CT平扫
男性患者,63岁,主诉憋气。胸部CT显示两肺大片状及类圆形实变影,边界模糊,内见充气支气管征,部分可见含气空腔
可见于多种疾病,包括各种原因引起的重症肺炎、过敏性肺炎(hypersensitivity pneumonitis,HP)、放射性肺炎(radiation pneumonitis,RP)、肺水肿(pulmonary edema,PE)、急性呼吸窘迫综合征(acute respiratory distress syndrom,ARDS)、弥漫性肺泡出血、隐源性机化性肺炎、肺泡蛋白沉积症、淋巴瘤和肺腺癌等。对于这类疾病,病变的分布对鉴别诊断有一定价值。例如,不对称性广泛实变影最常见于重症肺炎、过敏性肺炎和肺腺癌,而典型的肺水肿(图1-2-5)、ARDS、隐源性机化性肺炎和淋巴瘤肺浸润的肺实变影常呈对称性分布趋势;心源性肺水肿通常显示实变影以两肺门周围和下叶背段分布为主,X线胸片上呈典型的蝶翼征,CT表现常伴小叶间隔增厚及少量胸腔积液;ARDS的影像学表现可以与心源性肺水肿相似,但相当部分患者的实变影呈离心性分布,因此当两肺实变影呈离心性分布时更倾向于ARDS;当病变以两下肺胸膜下分布为主时,首先考虑隐源性机化性肺炎;放射性肺炎的影像学表现主要与放疗照射野有关,与肺叶或肺段无关,纵隔病变接受放射治疗后可表现为两侧纵隔旁对称性实变影,但是对于同步放化疗患者,放疗后出现的肺内实变影不典型,常可出现于放射野外。

图1-2-5 肺水肿X线胸片表现
床旁X线胸片显示两肺广泛实变影,以中下肺及肺门周围为著,右下肺野外侧带状致密影及肋膈角消失(提示右侧胸腔积液),心影增大
磨玻璃影(ground-glass opacity,GGO)是常见的胸部影像征象,表现为肺内密度增高,但不掩盖其内的血管和支气管影。在X线胸片上,磨玻璃影表现为肺密度增高,呈云雾状,通常较广泛,常伴肺纹理模糊,由于病变与正常肺组织前后重叠,常不易与肺实变影区别。而CT能明确区分磨玻璃影与实变影。磨玻璃影是一个非特异术语,一般用于HRCT描述,因为常规厚层CT图像上,容积效应也可使大片实变影边缘、小实变影或实性结节影呈磨玻璃密度,甚至小钙化灶表现为磨玻璃影。
磨玻璃影的辨认基于肺密度改变。CT上肺衰减值直接反映肺组织密度,但受其他诸多因素的影响。例如,肺窗条件常规使用1500HU(窗宽)和-700HU~-600HU(窗位),如果使用窄的窗宽和较低的窗位,可能出现假磨玻璃影;显示的磨玻璃影以薄层(0.5~1.5mm)为准,因为厚层CT可能因容积效应而遗漏小磨玻璃影,也可能把其他病变误认为磨玻璃影,如盘状肺不张;辨认磨玻璃影通常以深吸气末扫描为准,而呼气时肺密度增加,可形成假磨玻璃影;由于重力作用和下垂部分肺组织相对膨胀不全,可使该部分肺密度增加,易误认为磨玻璃影[深吸气或改变体位(如俯卧位扫描)时消失可排除磨玻璃影];扫描时呼吸运动或心脏搏动可形成运动伪影,也可误认为磨玻璃影,但叶间裂出现双裂征或血管影呈星芒状有助于辨别运动伪影。
磨玻璃影的病理学基础是肺泡内气体减少或框架结构增厚,包括肺泡腔部分填充、肺泡间质增厚(液体、细胞或纤维化)、肺泡部分萎陷、毛细血管容量增加等。因此可以看出,磨玻璃影同样也是一个非特异性征象,须根据病灶的形态、范围和分布进行鉴别。磨玻璃影可根据病变范围,分为局灶性及弥漫性两大类。
常见原因包括炎症、出血和肿瘤。在局灶性磨玻璃影的诊断过程中,首先须确定病灶是一过性还是持续性的。判断是否为一过性局灶性磨玻璃影,须短期内(1~3个月)复查。如果短期复查显示病灶明显缩小或消失,提示为一过性病变,一过性病变的可能原因为灶性炎症、灶性出血和灶性水肿。如果病灶无明确变化,则提示为持续性病变。对于持续性病变,应区分是纯磨玻璃影还是混合性磨玻璃影(即部分磨玻璃和部分实性高密度病变)。
磨玻璃结节(ground glass nodules,GGN):是局灶性磨玻璃影的一个特殊形式,即边界较清楚的球形或类球形磨玻璃影。持续存在的纯磨玻璃结节或混合密度结节是局灶性磨玻璃影中常见且较值得关注的形式。近几年来,由于低剂量CT肺癌筛查和肺部CT的广泛应用,磨玻璃密度结节检出率逐渐增多,对磨玻璃结节的诊断策略和方案已经比较成熟。对于持续存在的纯磨玻璃结节需考虑肺腺癌、非典型腺瘤样增生和局灶性纤维化。鉴别诊断原则是:直径<5mm纯磨玻璃结节考虑为非典型性腺瘤样增生为主;少数纯磨玻璃结节可能为局灶性纤维化,长期随访无变化;如果磨玻璃结节直径>5mm(图1-2-6),则有肺腺癌(原位腺癌、微浸润性腺癌或浸润性腺癌)可能,需密切观察,但纯磨玻璃结节相对生长速度很慢,通常需几年才显示有明确变化,倍增时间可超过800天;直径>10mm磨玻璃结节或复查时见病变明确增大,提示需进一步处理(穿刺活检或手术干预);对于混合密度结节(图1-2-7),如果短期内复查没有明显缩小,通常提示为恶性病变(混合密度结节的增长速度相对快于纯磨玻璃结节的增长速度,通常需要进行临床干预)。在肺癌筛查中发现多发磨玻璃结节并不少见,应按上述原则分别考虑,临床处理应重点关注主要病变,即病灶直径最大(>10mm)、实性成分比例最多(尤其是实性部分>5mm)者。注意,同一患者可以同时存在非典型腺瘤样增生、原位腺癌和浸润性腺癌不同病灶。




图1-2-6 原位腺癌影像学表现
男性患者,76岁。X线平片(A)显示左肺尖隐约密度增高;CT冠状位重组像(B)显示左肺尖类圆形磨玻璃影,边缘不规则;CT轴位肺窗显示本次(D)左肺尖磨玻璃密度影与10年前(C)同层病灶对比有明显增大




图1-2-7 左上肺浸润性腺癌影像学表现
男性患者,72岁,体检发现肺内病变。X线胸片(A)显示左肺尖小斑状密度增高影,于第三后肋内侧重叠;CT轴位肺窗(B)显示左肺尖混合磨玻璃结节,边缘较清楚,其内实性病变直径>5mm;CT冠状位(C)及矢状位(D)重组像显示病变形态及其与主动脉弓的关系
晕征和反晕征:也是局灶性磨玻璃影的特殊形式,通常单独存在,有时可同时并存。晕征在CT上表现为类圆形实性阴影周围被磨玻璃影环绕,主要见于真菌(如曲霉菌、毛霉菌、隐球菌)感染,非真菌(如病毒、分枝杆菌、诺卡菌、放射线菌或寄生虫等)感染以及肺腺癌、肉芽肿性多血管炎和结节病等非感染性疾病有时也可出现晕征(图1-2-8)。由此可见,晕征并非特异性CT征象。免疫抑制患者出现晕征,可首先考虑血管侵袭性真菌(尤其是曲霉菌)感染;如若患者无免疫功能受损,则考虑为出血性病变可能。反晕征在CT上呈局灶性圆形磨玻璃影被或多或少的实变环所包绕。反晕征最初被认为是隐源性机化性肺炎(cryptogenic organizing pneumonia,COP)的特征性表现,目前认为是一个非特异性征象,可见于感染性疾病(如毛霉菌、曲霉菌、结核和副球孢子菌感染)和非感染性疾病(如机化性肺炎或隐源性机化性肺炎、结节病、肺梗死和血管炎等)。临床上,对于免疫抑制患者,出现反晕征,可首先考虑真菌感染,尤其是毛霉菌感染;而对于临床考虑非感染性病变者,首先考虑COP,其他感染性疾病中结核相对常见,但其反晕征多为许多细小结节影(图1-2-9),由非典型实变影和磨玻璃影组成。


图1-2-8 两肺转移瘤胸部CT表现
男性患者,53岁,咯血。胸部CT显示两肺多发结节伴晕征,弥散分布,并见心包积液


图1-2-9 肺结核胸部CT表现
男性患者,43岁,有慢性咳嗽。胸部CT显示左肺可见多发反晕征,由许多细小点状高密度影组成
多累及双侧大部分或全部肺叶,既可以是肺实质病变,也可以是间质病变,但通常提示为活动性病变。可以产生弥漫性磨玻璃影的肺部疾病有很多,其影像学鉴别诊断相当困难。
根据HRCT所示形态特点,可将弥漫性磨玻璃影分为3个亚型:小叶中心磨玻璃影、弥漫性片状磨玻璃影和碎石路征。
(1)小叶中心磨玻璃影:
病灶较小,主要分布于小叶中心,通常提示疾病与气道有关,如呼吸性细支气管炎、亚急性过敏性肺炎、肺尘埃沉着病(尘肺)和慢性吸入性细支气管炎。呼吸性细支气管炎通常见于吸烟者,病灶较小且密度较低,主要分布于中上肺。亚急性过敏性肺炎病灶较明显,呈弥漫分布,病变与胸膜无直接接触(图1-2-10)。慢性吸入性细支气管炎的病变主要分布于两肺中下叶。尘肺急性期可表现为两肺弥漫小叶中心磨玻璃影或小结节影。



图1-2-10 过敏性肺炎胸部CT表现
男性患者,32岁,咳嗽3周。胸部CT(A、B)显示两肺弥漫小磨玻璃影,位于小叶中心,叶间胸膜及胸膜下未受累,右中叶外侧段可见小马赛克征;冠状重组像(C)显示病变呈弥漫分布,无明确分布区别
(2)弥漫性片状磨玻璃影:
两肺广泛斑片状磨玻璃影或呈均匀磨玻璃高密度影,可对称或不对称分布。临床上,不同疾病的影像学表现可以完全一样,因此这类影像相关疾病的鉴别诊断主要依靠临床病史,病变分布也有一定参考价值。根据临床特点,弥漫性片状磨玻璃影相关疾病可分为急性或慢性两大类。急性病变包括肺水肿、肺出血(图1-2-11)、病毒性肺炎(或肺孢子菌肺炎)、吸入性肺炎、急性呼吸窘迫综合征、急性嗜酸细胞性肺炎。慢性病变包括非特异性间质性肺炎(nonspecific interstitial pneumonia,NSIP)、胶原血管性肺疾病、药物性肺损伤(drug induced lung injury,DILI)、脱屑性间质性肺炎(desquamative interstitial pneumonia,DIP)、肺泡蛋白沉积症和肺腺癌(既往称为细支气管肺泡细胞癌)。对于急性病变,更多依赖临床表现进行鉴别。而对于慢性病变,病变分布有一定指导价值,如磨玻璃影主要分布于两下肺胸膜下,伴或不伴牵引性支气管扩张,提示NSIP可能性较大(图1-2-12)。DIP在临床上罕见,磨玻璃影分布更弥漫。肺泡蛋白沉积症及肺腺癌可呈广泛磨玻璃影,但通常不对称,尤其是肺腺癌。




图1-2-11 肺肾出血综合征影像学表现
男性患者,58岁,患肾炎。X线胸片(A)显示两肺野透亮度降低,隐约可见斑片状模糊影;CT冠状重组像(B)显示两肺广泛斑片状磨玻璃影,较对称;CT肺窗轴位像(C、D)显示两侧各肺叶均可见斑片状磨玻璃影,边界不清

图1-2-12 NSIP胸部CT表现
胸部CT显示两肺磨玻璃影,以胸膜下及下肺分布为著,伴胸膜下线和条状影
(3)碎石路征:
是一种特殊形式的磨玻璃影,HRCT特点为在磨玻璃影背景上重叠小叶间隔增厚及小叶内线状影,病变通常呈地图状分布,有正常肺相邻,且边界锐利。可出现碎石路征的肺部疾病包括肺水肿、肺孢子菌肺炎、黏液性肺腺癌、肺泡蛋白沉积症(图1-2-13)、结节病、非特异性间质性肺炎、机化性肺炎、外源性类脂性肺炎、急性呼吸窘迫综合征和肺出血综合征等。




图1-2-13 肺泡蛋白沉积症胸部影像学表现
男性患者,35岁。X线胸片(A)显示右下肺及左中下肺野密度增高,边缘模糊;轴位CT(B、C)显示两肺广泛碎石路征,以左下叶为著,部分呈地图状分布;CT冠状重组像(D)显示两肺碎石路征,以左肺及右下肺为著
对弥漫性磨玻璃影相关疾病的诊断和鉴别诊断应结合其形态、分布、伴随征象、病变的动态变化以及临床资料等因素综合考虑。对于其影像学表现,尤其是需要注意病变分布特点(中央性或外周性)和伴随征象(如小叶间隔增厚、牵引性支气管扩张、胸腔积液等),由于不同疾病谱影像学表现不同,所以病变的动态变化不仅有助于区别疾病的急性或慢性过程,而且其临床特点对鉴别诊断也十分重要,如肺水肿、肺出血和肺泡蛋白沉积症这3种疾病的影像学表现可以非常相似,但临床表现却完全不同。
肺内大片致密阴影伴所在肺体积缩小时应考虑为肺不张。胸部X线正侧位像通常可以直接诊断肺不张并准确定位(肺叶水平),但胸片无法判断引起肺不张的原因,常需进一步CT检查。CT的主要价值在于进一步观察所在肺叶支气管是否阻塞(图1-2-14),以判断肺不张原因。引起肺不张的常见原因为支气管管腔内阻塞或外部压迫,包括良恶性肿瘤、支气管结核、异物和黏液等。肺不张可分为单侧肺不张、肺叶肺不张和盘状肺不张。单侧肺不张影像显示患侧肺野致密变,患侧胸廓塌陷,纵隔及气管向患侧移位。不同肺叶肺不张在X线胸片上可呈不同形态,但基本病变相似。盘状肺不张在常规厚层CT可被误认为磨玻璃影而诊断为炎症(图1-2-15),薄层呈带状致密影有助于避免误诊。




图1-2-14 右下叶肺癌并肺不张胸部影像学表现
男性患者,76岁。X线胸片(A)显示右肺容积缩小,右肺门及水平裂下移,气管右移;增强CT纵隔窗动脉期像(B)显示右下叶支气管阻塞,局部可见未强化肿块影,其后方为不张肺组织;延迟扫描像(C)显示肿块影强化,密度与不张肺组织接近;肿块远端层面像(D)显示不张肺组织内血管聚拢,支气管内黏液潴留




图1-2-15 左下叶盘状肺不张胸部影像学表现
女性患者,69岁。常规轴位CT肺窗(A)显示左下叶后基底段隐约可见斑片状淡模糊影;HRCT肺窗(B、C)显示左下叶后基底段磨玻璃影;冠状重组像(D)显示左下叶后基底段横行条状影
发现钙化是诊断和鉴别诊断胸部疾病的重要依据,钙化常发生于退行性变或坏死组织内。X线片上,钙化灶呈肺野内高密度影。较大的钙化在X线平片上容易辨认,其密度与骨皮质相似。直径为5mm甚至更小的类圆形影,通常提示为小钙化灶。CT比X线胸片有更高的密度分辨率,达10倍以上,CT平扫纵隔窗上,钙化灶呈高密度白色影,容易辨认。在平扫CT上,CT值>200HU可考虑为钙化灶。薄层(<1mm)CT扫描是检出钙化灶最敏感的方法,常规扫描可能遗漏小钙化灶。
X线胸片上显示钙化,通常提示为良性病变,特别是位于肺尖或两上肺时,通常提示为陈旧结核灶。X线胸片所见结节或肿块内发现钙化,多提示为良性病变,恶性病变概率不超过1%。CT不仅能准确检出钙化,还能显示钙化灶的形态、分布以及含量。通过CT在恶性结节内发现钙化的概率大于13%。
肺内单纯钙化灶直接提示为陈旧性病变,无须进一步检查或随访。若为软组织病灶内含钙化灶时,则须进一步诊断和鉴别诊断。肺内病灶中的钙化形态对鉴别诊断有重要价值。例如,若结节中的钙化呈靶心状(图1-2-16)、层状、爆米花样及弥漫性,病变多为良性,如结核球和错构瘤。成骨肉瘤和黏液腺癌的肺转移病灶也可呈弥漫钙化或爆米花状钙化,但通常为多发性且有明确病史以供鉴别。若出现偏心性点状或不规则状细小钙化,应考虑恶性可能。
CT上显示两肺弥漫性钙化灶的疾病不多,主要见于转移性钙化和肺泡微石症。肺转移性钙化发生于钙磷代谢异常所致的高钙血症,常见疾病为慢性肾衰竭和继发性甲状旁腺功能亢进,CT表现为两肺大量小叶中心结节状致密影或磨玻璃影,内含点状钙化,临床结合血钙升高,可直接做出诊断。肺泡微石症是一种罕见疾病,影像表现为两肺弥漫点状钙化,以后部及两下肺分布为主,在胸膜下及支气管血管束旁明显,容易诊断(图1-2-17)。


图1-2-16 右上叶小结节内靶心钙化
CT肺窗(A)显示右上叶后段小圆形影,边缘光滑;CT骨窗(B)显示右上叶小结节内中心小钙化点




图1-2-17 肺泡微石症影像学表现
男性患者,41岁。X线胸片(A)显示两肺野透亮度明显降低,两中下肺野致密,心影不清,内见弥漫点状高密度影;胸部CT(B、C)显示双肺磨玻璃影和网状钙化影,类似碎石路征;CT纵隔窗冠状位重组像(D)显示两肺广泛点状及网状钙化影,较对称
结节和肿块的影像学表现为肺内球形和类球形病变,以长径≥3cm为肿块,长径<3cm为结节。肿块的恶性可能性相对更大,但当肿块直径>10cm时,良性病变的比例增大。
表现为肺实质内单个球形或类球形密度增高影,长径<3cm,病变内可有钙化或空洞,不伴有肺门或纵隔淋巴结肿大、肺不张和肺炎。
形成孤立性结节的原因很多,包括肿瘤性、炎症性、先天性等,鉴别诊断有一定难度。肿瘤性病变包括支气管肺癌、转移瘤、原发肺淋巴瘤、错构瘤、硬化性血管瘤、结缔组织和神经肿瘤(脂肪瘤、纤维瘤、软骨瘤、神经纤维瘤和肉瘤)等。炎症性又分感染性和非感染性:感染性炎症包括肉芽肿(结核和真菌性)、球形肺炎(急性或慢性)、肺脓肿和寄生虫病等;非感染性炎症包括类风湿性关节炎、肉芽肿性多血管炎、淋巴瘤样肉芽肿、结节病、类脂性肺炎和白塞病等。先天性病变包括动静脉畸形、肺囊肿、肺隔离症、支气管闭锁并黏液嵌塞。其他原因还有机化性肺炎、肺梗死、球形肺不张、肺内淋巴结肿大、黏液嵌塞、肺动脉瘤或静脉曲张等。
鉴别结节或肿块的影像学表现,首先是要判断其良、恶性,然后才是诊断疾病。鉴别诊断主要根据病灶大小、形态、边缘、其内密度、与周围血管或胸膜的关系。另外,还可以通过增强扫描,根据结节或肿块强化的方式和程度进行鉴别。
判断结节和肿块的主要征象包括:毛刺征、分叶征、胸膜凹陷征、血管集中征、彗星尾征、晕征、支气管充气征、空泡征、空洞、空气新月征、纯磨玻璃密度、混合磨玻璃密度、钙化、脂肪、星系征和卫星灶等,其良、恶性鉴别需综合上述多种征象进行判断。例如,肺内良性肿瘤表现为边缘锐利、光滑,生长缓慢;而恶性结节常表现为边缘不规则、呈分叶状(图1-2-18)或可见脐样切迹、短细毛刺或胸膜凹陷征等。值得注意的是,这些病变征象与病灶大小有一定关系,直径<1cm恶性结节的表现可类似良性结节。上述征象中最具诊断价值是结节内脂肪密度,结节内显示有脂肪密度(-120~-40HU),多数为良性病变,如果边界清楚且较光滑,考虑为肺错构瘤(图1-2-19),如果病灶边缘不规则,可能为类脂性肺炎。其次是钙化,CT主要观察钙化的类型,针尖状钙化或偏心性钙化可能为恶性病变(图1-2-20),弥漫钙化、靶心钙化、葱皮样钙化和爆米花状钙化考虑为良性病变。相对有价值的征象包括:毛刺征和分叶征提示为恶性病变的可能性较大;彗星尾征提示可能为球形肺不张;晕征提示病灶周围有出血;空气新月征提示为真菌性感染(图1-2-21);星系征提示结节病的可能;结节或肿块周围出现卫星灶提示结核可能性较大。
对于大多数孤立性肺结节,通过上述影像学分析,可以做出诊断,增强扫描有助于增加诊断的准确性。值得注意的是,对于增强扫描,单纯动脉期扫描价值有限,因此必须进行双期扫描(即动脉期和延迟期)。肺结节增强扫描密度与平扫密度相比,如果没有增加(变化<10HU),通常提示为良性;如果有轻到中度增加(增加20~60HU),提示有恶性可能;如果明显增高(>60HU),提示良性可能性大。另外,如果增强扫面见结节呈环状强化(图1-2-22),提示为炎性(结核球或脓肿)。

图1-2-18 右上叶肺转移瘤CT表现
男性患者,84岁,结肠癌晚期。CT肺窗显示右上叶肿块影,边缘呈分叶状及脐凹征


图1-2-19 右下叶肺错构瘤CT表现
男性患者,73岁。CT骨窗(A)显示右下叶椎体旁结节影,内见爆米花状钙化;CT纵隔窗(B)显示结节内除大量钙化灶外,周边可见些小的低密度脂肪灶(与胸壁皮下脂肪相似)


图1-2-20 左下叶肺癌结节CT表现
CT肺窗(A)显示左下叶胸膜下结节影,边缘不规则,可见短毛刺,内见小空泡征;纵隔窗(B)显示结节影内偏心、不规则钙化影


图1-2-21 右上叶霉菌球CT表现
CT肺窗(A)显示右上叶圆形影,其前缘可见新月形含气影;冠状重组像(B)显示右上叶新月形空洞




图1-2-22 左下叶肺脓肿影像学表现
男性患者,37岁,发热1周。胸部X线正位像(A)显示左下叶背段肿块影;胸部X线侧位像(B)显示病灶边缘不清;胸部增强CT(C、D)显示左下叶肿块影内大部分呈液性密度,伴气液平面,周边可见环状强化

图1-2-23 结肠癌两肺转移瘤胸部X线表现
男性患者,80岁。胸部X线正位像显示两肺多发结节影,大小不等,以中下肺分布为著
目前一般认为,直径<1cm为小结节,直径≤3cm为大结节。大结节有两类:一类为肺浸润性结节,最常见于血行转移瘤,其他还有弥漫性肺腺癌、肉芽肿性多血管炎、淋巴瘤和感染等;另一类是肺内融合结节,主要见于结节病、硅沉着病(矽肺)和煤工肺等。典型的血行转移瘤容易诊断,影像学表现为两肺散在分布大小不等的结节,边缘光滑,呈软组织密度,通常略有两下肺及后部分布倾向性(图1-2-23)。少数转移瘤影像学表现可以出现空洞(图1-2-24)、钙化或边缘不规则。肉芽肿性多血管炎影像学表现为结节数量通常不多,并且较大结节容易出现空洞。感染性结节多为播散性感染,如结核及真菌感染,影像学表现通常为结节边缘不光滑,如果出现晕征,有助于真菌性感染的诊断。融合结节也称星云征,其结节影其实是由无数细小结节堆积而成的,中央较致密,以双上肺多见,主要见于尘肺和少数结节病。


图1-2-24 左下叶肺腺癌术后两肺转移瘤CT表现
CT显示两肺弥漫结节影,呈弥散分布,部分结节内有小空洞形成
对于小结节,可根据结节的密度以及与小叶结构的关系进行鉴别。首先,判断小结节影是否有钙化,出现钙化小结节,主要考虑陈旧性肉芽肿病变(如肺结核)、含钙化的血行转移瘤(如成骨肉瘤和消化道黏液腺癌)等。对于弥漫性小结节影,根据小结节与小叶结构的关系,可分为弥散随机分布、淋巴道周围分布和小叶中心分布。出现弥散随机分布小结节最典型的疾病是粟粒性肺结核(图1-2-25),其他还有血行肺转移瘤和一些真菌感染,偶可见于尘肺和结节病。沿淋巴道周围分布的小结节主要位于支气管血管束周边、小叶间隔、胸膜下和小叶中心间质等部位,常见于结节病(图1-2-26)和癌性淋巴管转移,也可见于尘肺和一些淋巴增生性疾病。小叶中心分布的小结节可能与支气管有关,也可与血管有关,因此其所涉及的病变较广泛,但以过敏性肺炎及细支气管炎常见。
树芽征是小结节影呈小叶中心分布的一种特殊表现,反映细支气管扩张,腔内充满黏液、液体或脓液等,通常合并有细支气管周围炎症。在HRCT上,其典型表现是小叶中心的分支影末端膨大或见小结节而呈类似树发芽改变。由于小叶中心的立体结构与HRCT层面的关系,树芽征可以有其他不同表现,如距胸膜面数毫米处见簇状微结节,甚至在肺底部可见孤立的小叶中心微结节。采用最大密度投影(maximum intensity projection,MIP)后处理技术可以更好显示树芽征(图1-2-27)。




图1-2-25 粟粒性肺结核胸部CT表现
女性患者,70岁。CT轴位肺窗(A~C)显示两肺弥漫小点状影,大小相似,呈随机均匀分布;冠状位重组像(D)显示两肺粟粒结节影呈弥漫分布,无上下肺野分布区别


图1-2-26 结节病胸部CT表现
CT肺窗显示两肺弥漫细小结节影,沿叶间裂、肋胸膜及肺门周围血管缘分布,呈典型的淋巴道分布


图1-2-27 肺结核胸部CT表现
CT轴位肺窗(A)显示右上叶沿支气管分布的小点状影,左上叶后胸膜下斑片状实变影及小点状影;冠状MIP重组像(B)能更好地显示小点状影与支气管的关系,树芽征更为清晰
树芽征是鉴别诊断中相当有价值的征象,常见于结核支气管播散、感染性细支气管炎、各种原因支气管扩张并感染、弥漫性泛细支气管炎和囊性纤维化。结核支气管播散的树芽征常沿支气管血管束分布,如同时发现有空洞影或大支气管增厚、狭窄,提示结核可能性大;感染性细支气管炎的树芽征通常呈肺叶或肺段性分布,短期复查可见明显变化;弥漫性泛细支气管炎的树芽征表现为两肺较对称,以两下肺为主,可伴相对较轻的支气管扩张。如果树芽征是由支气管扩张所致,则支气管扩张范围明显大于树芽征的范围。囊性纤维化影像表现类似弥漫性泛细支气管炎,但支气管扩张改变更为明显,且该病在亚洲人群中非常罕见。
空洞是肺内病变发生组织坏死、液化,并经支气管引流排出而形成的,如结核灶发生干酪样坏死、肺脓肿或肺癌的液化坏死等。空洞性病变与局灶性病变中有空洞形成的区别在于后者为病灶内有小空洞,而前者则空洞占病灶大部分。
引起肺内空洞病变的疾病主要包括恶性肿瘤(肺癌和转移瘤)、感染(脓肿或坏死性肺炎、结核、脓毒血症、气管支气管乳头状瘤病、肺真菌病)、非感染性炎症(结节病、肉芽肿性多血管炎和类风湿结节)和其他(肺隔离症、肺挫裂伤和肺梗死后等)。
影像学对肺内空洞性病变的鉴别诊断主要是通过观察壁的厚薄(壁厚≤3mm为薄壁,≥5mm为厚壁)、内壁光滑或不规则(的影像学分析与孤立性肺结节相似)、有无壁结节、中央性或偏心性空洞等确定其良、恶性。在CT显示为薄壁且内壁光滑者几乎均为良性。对于厚壁空洞,即使CT显示内壁不光滑也不一定是恶性结节,须结合空洞外缘的影像特点综合考虑(图1-2-28)。但是,如果壁厚>15mm且内壁不规则,通常提示为恶性病变(图1-2-29)。


图1-2-28 右上叶肺脓肿X线胸片表现
男性患者,32岁。胸部X线正、侧位片显示右上叶空洞影,内见气液平面,外缘模糊


图1-2-29 右上叶肺癌CT表现
CT 纵隔窗(A)显示右上叶后壁空洞影,内壁不光滑;CT肺窗(B)显示病灶边缘不规则,可见毛刺
肺囊状影指肺内原有含气腔隙异常扩大。囊壁通常由成纤维细胞或上皮细胞组成。在HRCT上,肺囊状影指肺内薄壁(通常<2mm)、边缘清楚锐利的含气腔,多不伴有肺内纤维化。囊状影的直径差异较大,与病程有密切关系。在病变早期,囊腔直径较小,可以仅为数毫米,而在病变晚期则可达数厘米。
肺囊状影须与其他含气间隙,如肺大疱、胸膜下肺小疱和肺气肿等区别。后几种含气腔隙都无明确囊壁,不是真正的肺囊状影。有时,较大的肺大疱可压迫周围肺组织或合并感染而形成假壁。一般说来,肺囊状影直径多<3cm,而可见假壁肺大疱的直径往往>3cm,甚至>10cm。
HRCT显示广泛、多发的肺囊状影,一般提示为肺淋巴管平滑肌瘤病或肺朗格汉斯细胞组织细胞增生症。前者见于育龄期女性,囊状影呈两肺弥漫、对称分布(图1-2-30),无上肺或下肺分布区别;后者多见于吸烟男性,囊状影以两上肺分布为主(图1-2-31),肺底部几乎正常,并且形状不规则,可呈多种奇怪形状。其他表现为肺囊状影的疾病还有淋巴细胞性间质性肺炎(lymphocytic interstitial pneumonia,LIP)和肺孢子菌肺炎(pneumocystis carinii pneumonia,PCP)等。LIP的囊状影多出现在胸膜下和支气管血管束周围(图1-2-32),且多见于干燥综合征患者。肺孢子菌肺炎的囊状影通常以上肺较多见,并且多伴广泛磨玻璃影。
囊状支气管扩张是囊状影的一种特殊形式,可呈多发囊状影,常呈沿支气管血管束的肺叶或肺段分布,典型者可呈葡萄串状,少数患者可累及多个肺叶但仍沿支气管血管束分布,且连续薄层CT图像可显示囊状影与支气管相通,其囊壁常较厚,囊内可见气液平面(图1-2-33)。囊状支气管扩张在X线胸片上不易显示,目前HRCT是支气管扩张最敏感的无创性诊断方法。




图1-2-30 肺淋巴管平滑肌瘤病胸部CT表现
女性患者,33岁。CT轴位肺窗(A~C)显示两肺弥漫薄壁囊状影,两侧对称,囊状影之间的肺组织基本正常;冠状重组像(D)显示两肺弥漫囊状影,上肺病变较重


图1-2-31 肺朗格汉斯细胞组织细胞增生症胸部CT表现
男性患者,48岁。CT肺窗显示两肺广泛囊状影,较大囊状影呈不规则或奇怪形状,肺底部囊状影明显减少


图1-2-32 LIP胸部CT表现
女性患者,40岁,患干燥综合征。CT肺窗(A)显示两肺多发囊状影,血管周围及胸膜下分布为主;CT冠状重组像(B)显示多发囊状影,下肺较多




图1-2-33 支气管扩张影像学表现
男性患者,59岁。胸部X线正位像(A)显示两肺支气管壁增厚,右中肺野可疑囊状影;胸部X线侧位像(B)显示相当于中叶处可见多发囊状影;CT轴位肺窗(C、D)显示两肺多囊状影,沿支气管血管束成簇分布
HRCT上,肺内线状或(和)网格状影是肺间质性疾病的最常见表现。根据病灶累及肺小叶的结构和位置,影像学改变主要包括小叶间隔增厚、小叶中央异常、网状影、蜂窝影、胸膜下线影、界面征、支气管血管束周围增厚和不规则线状影等。小叶间隔增厚、网状影和蜂窝影有助于间质性肺疾病的诊断,其他线状或网格状影通常是伴随阴影。
正常人的小叶间隔厚度约为0.1mm,很难在HRCT中直接显示,偶尔隐约可见垂直于胸膜面、长约1cm的细线状影。如果在HRCT上较多或广泛地显示小叶间隔线,提示为间质异常。HRCT上,增厚的小叶间隔可长达1~2.5cm,位于肺外周,直达胸膜面,相邻小叶间隔可围成一个多边形结构,之中见分叉状或点状的小叶中心动脉。
小叶间隔增厚可以是间质液体成分增多、细胞浸润或纤维化等因素所致,相关疾病主要包括肺水肿、癌性淋巴道转移、普通型间质性肺炎(usual interstitial pneumonia,UIP)、结节病、肺静脉狭窄、肺泡蛋白沉积症、静脉闭塞性疾病等。若患者肺部HRCT表现为小叶间隔增厚,应首先区分光滑增厚、结节状或不规则状增厚。如果小叶间隔光滑增厚,且两侧对称分布,上肺或外周性分布为主,可考虑为间质性肺水肿(图1-2-34),以心源性肺水肿最常见(如同时可见两侧少量胸腔积液、心影增大,更有助于诊断);如果小叶间隔光滑性增厚,但不对称,部分呈结节状小叶间隔增厚,应考虑癌性淋巴道转移(图1-2-35)或结节病(如果有同侧肺癌病灶或已知有肺外恶性肿瘤病变,应考虑前者;如果伴纵隔及两肺门广泛淋巴结增大,临床症状不明显,可考虑结节病的可能);如果小叶间隔光滑增厚,伴磨玻璃影,且以地图状分布,首先考虑肺泡蛋白沉积症;如果两侧肺广泛小叶间隔光滑增厚,同时伴主肺动脉及两侧肺动脉增粗,应考虑肺静脉闭塞性疾病(这是一种罕见疾病,为肺动脉高压罕见病因之一);对于以结节状或串珠状小叶间隔增厚为主者,首先考虑癌性淋巴道转移,其他可见于结节病和尘肺等(结合病史容易鉴别);小叶间隔呈不规则状,多提示为间质性纤维化,但通常伴网状影或蜂窝影等改变,且主要见于远离网状影和蜂窝影的区域。
CT可见肺内细线状影交织,与渔网相似,网内为肺实质密度而非空气密度,通常提示间质性纤维化,主要病因包括特发性肺纤维化(idiopathic pulmonary fibrosis,IPF)、非特异性间质性肺炎(NSIP)、结缔组织疾病(connective tissue disease,CTD)、慢性过敏性肺炎、结节病、石棉肺和药物性肺损伤。鉴别诊断时,首先观察网状影的分布:如果表现为两下肺外周性分布,伴蜂窝影,考虑为普通型间质性肺炎(UIP);如果不伴蜂窝影,可能为NSIP、IPF或结缔组织疾病等(图1-2-36);慢性过敏性肺炎也可表现为两肺网状影,但主要分布于两中上肺野;结节病的网状影主要以中上肺及肺门周围分布为主;石棉肺的网状影与IPF相似,同时两侧肋胸膜及膈肌胸膜有胸膜斑和钙化有助于鉴别诊断(图1-2-37)。




图1-2-34 间质性肺水肿影像学表现
CT轴位肺窗(A、B)显示两上肺小叶间隔光滑增厚,中间可见小斑状磨玻璃影;抗心力衰竭治疗后CT轴位像(C、D)显示原两上肺小叶间隔增厚及磨玻璃影完全消失


图1-2-35 癌性淋巴道转移胸部CT表现
女性患者,42岁。CT冠状重组像显示右肺广泛小叶间隔增厚及小叶内磨玻璃影,左侧基本正常,右下肺可见结节影(原发肺腺癌)


图1-2-36 系统性硬化症胸部CT表现
女性患者,45岁。CT肺窗显示两肺胸膜下细网状影,伴牵引性支气管扩张


图1-2-37 石棉肺胸部CT表现
CT肺窗显示两侧肋胸膜及右膈肌多发胸膜斑,两下肺胸膜下可见胸膜下线及条网状影
是具有特征性诊断价值的一个HRCT征象——发现肺内蜂窝影,即可诊断肺间质纤维化,而且通常提示为肺纤维化末期,治疗难以逆转,主要见于普通型间质性肺炎(UIP)、石棉肺,少见疾病包括结节病和急性间质性肺炎的慢性期。HRCT显示为成簇囊性气腔,直径通常为3~10mm,偶尔可达25mm,通常在胸膜下分布,且有明确、清楚的囊壁(图1-2-38),少数可呈较广泛分布或灶性分布。X线胸片检出蜂窝影的敏感性和特异性均低,显示为环状影,典型呈直径3~10mm,壁厚1~3mm,呈蜂窝样改变,提示末期肺部疾病。
蜂窝影通常被认为是UIP的特征性改变,因此这一定义必须谨慎使用。根据2011年《特发性肺纤维化诊治指南》,当影像学表现为两侧网状影、蜂窝影,病变在肺基底部和外周分布,而无其他不符合UIP的表现(两肺广泛磨玻璃影、实变影、结节影、囊状影或马赛克征等)时,考虑为典型UIP。结合临床,若无其他引起UIP的原因,无须病理活检即可直接诊断IPF。如果无蜂窝影的上述HRCT特征,只能考虑为“可能UIP表现”,通常建议进行肺活检以确诊。




图1-2-38 特发性肺纤维化胸部CT表现
CT轴位肺窗(A、B)显示两肺胸膜下蜂窝影,以下肺分布为主;X线胸片(C)显示两肺网状影,以外带及两下肺分布为主;冠状CT重组像(D)清晰显示蜂窝影及网状影
肺气肿是一病理学定义,指终末细支气管远端气腔持久性异常增大,累及气腔壁破坏,但无明显肺纤维化。HRCT是目前诊断肺气肿最敏感的无创性检查方法。当使用适当低窗位(-800~-600HU),配合窄窗宽(800~1000HU)时,肺气肿的低密度透亮区很容易与周围正常肺的稍高密度相区别。采用计算机辅助诊断(computer aided diagnosis,CAD)方法可以定量肺气肿的程度,且与肺功能检查有较好的相关性。
肺气肿可分为4个亚型,即小叶中心型肺气肿、全小叶型肺气肿、间隔旁型肺气肿、瘢痕旁型肺气肿。
小叶中心型肺气肿:是最常见的类型,与吸烟有明显关系。HRCT显示为肺野内出现散在分布的小圆形、无壁、低密度区(图1-2-39),直径为2~10mm,位于肺小叶中央,这些小透亮灶的边缘通常不清楚,但当直径>1cm时,部分边缘变得较锐利,可能是周围的小叶间隔或血管影。病变分布以两上肺较明显,下肺相对较轻。肺气肿的低密度灶与肺囊状影不同,缺乏明确且较完整的壁。随着病变进展,小叶中心病灶融合成较大范围的低密度区时,易与全小叶型肺气肿相混淆,但可根据病变分布特点及其他部位残留的小灶性无壁透亮区进行鉴别。


图1-2-39 小叶中心型肺气肿胸部CT表现
男性患者,57岁。CT显示两肺弥漫低密度透亮灶,部分融合,大多数无明确壁,上肺野比中肺野明显
全小叶型肺气肿:CT特点是小叶内较均匀的破坏而形成较大范围的低密度区,无明显边界,病变区内血管纹理明显减少。病变分布特点为两肺内弥漫分布但不均匀,通常以下叶及前部为重。病理上重度肺气肿与全小叶型肺气肿有时无法鉴别,但病变的分布特点有助于鉴别。
间隔旁型肺气肿:CT特点为胸膜下小透亮灶,通常呈单行排列(图1-2-40)。病变分布以两上肺,尤其是肺尖部为主,也常见于奇静脉食管隐窝。
瘢痕旁型肺气肿:CT可见肺内纤维灶周围小透亮灶,容易诊断。


图1-2-40 间隔旁型肺气肿胸部CT表现
男性患者,59岁。胸部CT显示两上肺胸膜下小透亮灶,无明确囊壁,呈单层排列,右肺较明显
肺大疱是肺气肿的一种特殊表现,即透亮区直径>1cm,边缘锐利,且壁厚≤1mm,HRCT能做出正确诊断。一般说来,肺大疱作为肺气肿的唯一征象是极为少见的,除了少数间隔旁型肺气肿患者仅表现为肺尖部肺大疱,通常肺大疱多合并其他型肺气肿,特别是小叶中心型肺气肿。在HRCT上,肺大疱直径多为2~8cm,最大可达20cm,单发或多发,分布常呈不对称,多见于胸膜下区。如果肺部病变以多个巨大肺大疱为主,也可称为大疱性肺气肿(图1-2-41)。


图1-2-41 大疱性肺气肿胸部CT表现
男性患者,46岁。胸部CT显示两肺多发大小不等透亮灶,无完整壁,最大的肺大疱位于左上肺,直径>10cm
影像学所见肺实质密度是肺内含气量、血流灌注量、血管外液量和肺组织密度的综合反映,正常约80%为气体、10%为液体、10%为组织结构。任何原因引起的局部肺气体量增多或液体量和组织结构成分减少,均可产生肺低密度影。
由于气道疾病或肺血管性疾病引起相邻肺区血液灌注差别,可在HRCT显现不均匀肺密度,常呈斑片状分布,形似建材中的马赛克,故称马赛克征(图1-2-42)。


图1-2-42 马赛克征胸部CT表现
女性患者,72岁,患哮喘。CT肺窗显示两侧肺实质通气血流灌注不一,边界清晰,两侧支气管管腔变细
气体陷闭是指在呼气相的不同阶段,CT肺窗显示肺野局限性、不均一性空气滞留的征象,即在呼气相CT中出现的马赛克征。气体陷闭是由于小气道病变导致通气不良的结果。正常人吸气时气道扩张,呼气时气道回缩;当病变使气道变窄时,容易导致气道在呼吸过程中呈活瓣状,使远端肺泡内有过多的气体潴留。引起气体陷闭的原因多样,如肺气肿、哮喘、慢性阻塞性肺疾病(慢阻肺)及各种原因所致的缩窄性细支气管炎,支气管扩张的远端肺组织也常见气体陷闭。有些血管性病变可引起马赛克征象,如慢性肺血栓栓塞征,但并非特征性征象,当临床有怀疑时,须行肺动脉CT造影以明确诊断。
单侧透明肺(Swyer-James综合征)(图1-2-43)表现为一侧肺过度充气伴血管稀疏,往往是婴幼儿期重症肺部感染后患侧肺毁损或发育不良伴缩窄性细支气管炎(或闭塞性细支气管炎)的一种特殊情况。



图1-2-43 单侧透明肺胸部CT表现
CT轴位肺窗(A、B)显示左侧肺实质大部分透亮度明显增高,其内血管影稀疏、纤细,右肺可见少许空气潴留改变;CT冠状重组像(C)显示两肺网状影,以外带及两下肺分布为主
可见于多种累及支气管的疾病,主要包括支气管扩张、支气管哮喘、下呼吸道病毒性感染和慢性支气管炎等,也可见于一些无症状吸烟者。对于支气管壁增厚,目前尚无统一评价标准,多根据主观视觉评价,与观察者经验有很大关系。一般而言,支气管壁厚至少2倍于同级正常支气管壁厚度即为支气管壁增厚,但是这一标准只有在与正常支气管比较后才成立。值得注意的是,支气管壁厚度的测量结果与扫描时患者吸气程度以及评价时所用窗条件(显示支气管壁的理想窗条件为窗宽1000HU、窗位-700HU)有关。在鉴别诊断中,支气管壁增厚本身意义不大,多须结合其他伴随征象。例如,支气管壁增厚伴支气管扩张,考虑为支气管扩张症;伴支气管管腔明显变细,考虑可能为支气管哮喘;下呼吸道病毒感染和慢性支气管炎也可出现支气管壁增厚(图1-2-44),主要根据临床病史(急性或慢性)加以鉴别。

图1-2-44 支气管炎胸部CT表现
CT肺窗显示两下叶支气管壁明显增厚,管腔稍变细
目前,HRCT是诊断支气管扩张最敏感和最有效的无创性检查方法。其直接征象包括:①支气管内径大于相邻肺动脉管径(图1-2-45),单个轴位层面支气管内径大于伴随肺动脉1.5倍,典型扩张支气管环状透亮影与相伴管径较小的肺动脉影可形成特征性的印戒征;②正常支气管管径逐渐变细的征象消失,即远段支气管管径等于或大于近段支气管管径(图1-2-46);③距肋胸膜1cm内可见支气管。诊断时要注意如下几点:①当CT层面上支气管和伴随肺动脉呈卵圆形时,应测量其短径。②长期居住高海拔者的肺动脉通常较细,在正常状态下支气管内径也可大于伴随的肺动脉。③当肺血流减少使相应肺动脉管径变细时,相对于正常大小的支气管可形成假印戒征。如果肺血流减少为区域性或单侧性的,与对侧相比较可以发现两侧支气管内径相似而血管影有明显差别;如果两侧肺血流均减少,通过远段支气管管径是否呈逐渐变细加以判断。④在一些左向右分流的心脏病患者中,由于肺灌注增多导致肺动脉管径增大,也可出现假阴性可能。总之,在诊断支气管扩张时。除了观察支气管与伴随肺动脉的管径外,还需结合支气管管腔是否逐渐变细这一征象进行判断。


图1-2-45 支气管扩张胸部CT表现
CT肺窗(A)显示右上叶前段支气管管腔不规则,远端明显扩张;下肺层面(B)显示两下叶多发支气管扩张呈囊状改变

图1-2-46 柱状支气管胸部CT表现
CT肺窗显示右下叶支气管扩张,呈双轨征,远端支气管管腔不呈逐渐变细
支气管扩张在形态上分4个亚型,即柱状、囊状、曲张性和混合性。支气管扩张的病因多种多样,最常见的为感染,少见的包括过敏性支气管肺曲霉菌病(allergic broncho pulmonary aspergillosis,ABPA)、纤毛不动综合征、免疫抑制、黄指甲综合征等。ABPA支气管扩张多为中心型,以肺门周围明显,常伴黏液潴留,可见气液平面,临床有哮喘表现;纤毛不动综合征者,支气管扩张位于中下叶,常伴内脏转位和鼻窦炎(即Kartagener综合征)(图1-2-47)。而牵拉性支气管扩张继发于肺纤维化,管壁不规则,通常不含黏液,与上述支气管扩张在形成机制上有本质的不同。




图1-2-47 Kartagener综合征胸部CT表现
CT轴位肺窗(A、B)显示两肺多发支气管扩张,部分内含黏液;X线胸片(C)显示心影位于右侧,两肺纹理明显增粗;冠状CT重组像(D)显示两肺支气管扩张,右下叶可见支气管内黏液栓,主动脉结位于纵隔右侧,中央支气管分支呈镜像分支(即左侧上叶支气管分支近气管分叉,而右侧主支气管较长
X线胸片仅可检出明显肺门淋巴结肿大,但是难与其他肺门肿块相鉴别,对于检出纵隔淋巴结肿大的敏感性较低,除非明显超出纵隔轮廓,并且也无法与其他纵隔肿块相鉴别。CT能准确发现纵隔和肺门淋巴结增大,增强扫描能更容易区别血管或淋巴结,当然也能显示增大淋巴结的强化特点,有助于鉴别诊断。在CT上,目前比较通用的判断标准是淋巴结短径>1cm时考虑淋巴结增大,对于隆嵴下淋巴结的判断可适当放宽标准,而对于主动脉弓和主肺动脉旁区、内乳淋巴结和心周淋巴结,即使接近1cm,也应视为异常。
引起纵隔和肺门淋巴结肿大的常见疾病包括恶性肿瘤淋巴结转移、淋巴瘤、结核性淋巴结肿大、结节病、Castleman病(巨大淋巴结增生症)和淋巴结反应性增生。单发巨大淋巴结增大多考虑Castleman病(多位于右侧气管旁)和淋巴瘤(多位于前纵隔)(图1-2-48)。两侧肺门及纵隔多发淋巴结增大首先考虑结节病(图1-2-49)。结核性淋巴结肿大多位于气管右旁。转移性淋巴结增大的分布主要与原发病灶位置有关。例如,原发性肺癌则多为同侧肺门及纵隔淋巴结增大(图1-2-50),对侧肺门淋巴结增大罕见;胸外原发性恶性肿瘤则以纵隔淋巴结增大为主,偶可见单侧淋巴结肿大。反应性淋巴结增生通常呈淋巴结轻度增大。增强扫描对于增大淋巴结的鉴别有重要价值。例如,CT值超过100HU且为单发巨大淋巴结增大时,首先考虑Castleman病;典型结核性淋巴结增大呈环形强化,中央无强化(图1-2-51);多发淋巴结增大且强化明显时,考虑结节病和某些转移性淋巴结增大(如肾癌、甲状腺癌和黑色素瘤)。淋巴结增大且钙化主要考虑结节病、尘肺、某些恶性肿瘤转移(消化道黏液腺癌、成骨肿瘤等)。


图1-2-48 前纵隔淋巴瘤胸部CT表现
CT轴位肺窗(A)显示前纵隔增宽:CT平扫纵隔窗(B)显示血管前区肿块影,与主动脉弓分界较清


图1-2-49 结节病CT表现
CT增强扫描纵隔窗显示纵隔及两肺门多发淋巴结肿大,两侧对称


图1-2-50 右侧中间支气管小细胞癌CT表现
CT增强扫描纵隔窗(A)显示右下肺门肿块影,中间支气管阻塞;较高层面(B)显示右肺门及隆嵴下淋巴结肿大


图1-2-51 纵隔淋巴结核CT表现
CT增强扫描纵隔窗显示气管右旁及上腔静脉前方淋巴结增大,中央呈低密度,边缘呈环形强化
在临床诊断过程,如何解读胸部影像并无统一模式。有经验的医师会根据自身经验积累和所掌握的知识形成自身的习惯进行解读。对于年轻医师,建立和培养一种良好的影像分析思路,并且不断实践,无疑将有助于逐步提高诊断水平。在此介绍一种比较通用的影像诊断分析思路,主要步骤包括:①发现异常影像征象;②分析各种异常征象并找出一个或一组主要的影像表现;③提出若干可能的疾病(包括常见、少见和罕见疾病)并进行鉴别;④最后结合临床资料提出影像诊断。这种诊断思维模式可能与临床医师熟悉的模式不同,因为临床医师更多是以临床特点主导,再结合影像特点进行诊断,虽然简便有效,但容易受先入为主的临床表现影响而出现诊断偏差,另外在患者临床表现无特点时则会有无从入手的感觉。上述介绍影像分析思路以影像征象入手,减少了临床因素干扰,有助于更客观地进行分析。采用这一方法对以临床为主的思维模式进行补充,相当于换一种角度思维,也符合在呼吸系统疾病诊断中强调的临床-影像-病理多学科协作理念。具体方法如下:
1.发现异常影像征象是影像诊断的基础,因此首先要仔细观察,正确识别各种异常征象,包括病变位置和分布特点。对于弥漫性病变,主要征象的分布特点尤其重要,包括两侧对称或不对称(甚至单侧性)、上肺分布或下肺分布、中央性分布或外周性分布;对于在小叶内结构的分布,分为小叶中心分布、淋巴道分布或弥散随机型分布。
2.不同患者的影像检查可显示一个或多个异常征象。对于单一征象,需要知道这一征象可见于哪些疾病,包括常见、不常见或罕见疾病。同时有多种征象时,则需要选择其中一种作为患者的主要征象,以便列出可能疾病供进一步鉴别。对单一征象或主要征象能列出多少种疾病,与每个解读者的知识和经验密切相关。
3.对已经列出的可能疾病,根据已知的主要异常征象、其他次要征象以及病变的分布特点逐一进行鉴别,缩小诊断范围或提出较明确的诊断。在此特别强调,应注意患者病变的动态变化,如果有可能,尽量获得患者以前所做的相关影像学检查。有时,动态变化可以在诊断中起决定性作用。
4.上述诊断过程,除一些有明确特征或以形态学诊断为主的疾病外,对于大多数患者主要是缩小诊断范围。结合临床相关检查资料将有助于进一步缩小诊断范围,甚至做出诊断。
(陈起航)
1.Hansell DM,Bankier AA,MacMahon H,et al.Fleischner Society:glossary of terms for thoracic imaging.Radiology,2008,246(3):697-722.
2.Lee HJ,Lee CH,Jeong YJ,et al.IASLC/ATS/ERS International Multidisciplinary Classification of Lung Adenocarcinoma:novel concepts and radiologic implications.J Thorac Imaging,2012,27(6):340-53.
3.Webb WR.Radiologic evaluation of the solitary pulmonary nodule.Am J Roentgenol,1990,154(4):701-708.
4.Rossi SE,Erasmus JJ,Volpacchio M,et al.“Crazy-paving”pattern at thin-section CT of the lungs:radiologic-pathologic overview.Radiographics,2003,23(6):1509-1519.
5.Raoof S,Amchentsev A,Vlahos I,et al.Pictorial essay:multinodular disease:a highresolution CT scan diagnostic algorithm.Chest,2006,129(3):805-815.
6.American Thoracic Society,European Respiratory Society.International Multidisciplinary Consenus: Classification of the Idiopathic Interstitial Pneumonias.Am J Respir Crit Care Med,2002,165:277-304.
7.Raghu G,Collard HR,Egan JJ,et al.An official ATS/ERS/JRS/ALAT statement:idiopathic pulmonary fibrosis:evidence-based guidelines for diagnosis and management.Am J Respir Crit Care Med,2011,183(6):788-824.
8.刘士远,陈起航,吴宁.实用胸部影像诊断学.北京:人民军医出版社,2012.